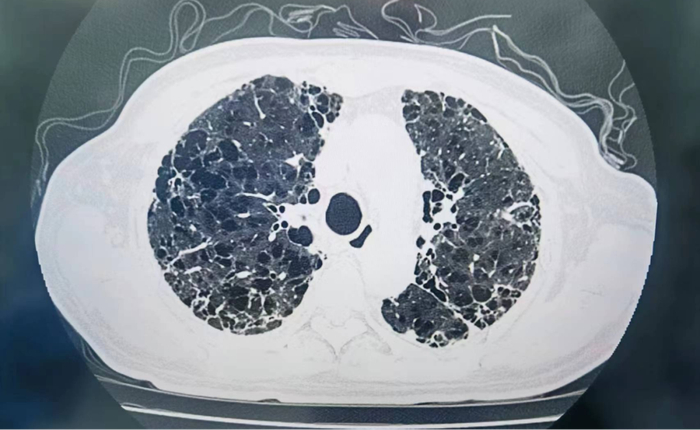

转自:医学界
“刚开始我们做单肺移植可能需要五六个小时,随着团队技术的成熟和不断改进,如今,我们一台单肺移植两三个小时就可以完成。”
人的生命离不开呼吸,有些人却因疾病常年遭受“呼吸之痛”,肺功能持续恶化、长期卧床毫无生活质量,对于这些终末期肺疾病患者来说,肺移植是唯一的选择。器官移植不同于其他手术,难度高、风险大,更离不开器官捐献者的伟大爱心捐献。
日前,广州医科大学附属第一医院国家呼吸医学中心何建行教授、徐鑫教授团队在12小时进行6台肺移植手术,其中4例同时开展,术后5人在手术室内拔除气管插管,目前,患者均在ICU顺利恢复之中,让四位器官捐献者的大爱得以传递,感恩他们的爱心捐献。

彻夜奋战
两例肺移植接续开展
8月15日深夜十二点,广州医科大学附属第一医院大坦沙院区的手术室里灯火通明,器官移植科的两个小组团队正在紧张地进行着这一天最后两台大手术——肺移植。
尽管白天他们已经做了多台普通胸外科手术,但得知有捐献的消息,团队没有丝毫犹豫,立即着手准备,多学科团队为此彻夜奋战。
据悉,手术患者年龄都不到六十岁,却已经是终末期间质性肺病,需要每天24小时持续吸氧或依赖呼吸机才能勉强维持生命。
随着医疗技术的进步和人们意识的转变,对器官移植的接受程度越来越高,对于一些晚期肺部疾病的患者来说,肺移植是帮助他们延长生命、改善生活质量的唯一希望。
十多年前,肺移植手术的难度和风险都相当高,器官移植学科带头人何建行教授带领团队自2003年成功开展第一例同种异体肺移植手术以来,至今已经积累了680多例手术经验。
“刚开始我们做单肺移植可能需要五六个小时,随着团队技术的成熟和不断改进,如今,我们一台单肺移植两三个小时就可以完成。”器官移植科主任徐鑫表示,技术的改进大大缩短了手术时间,更加有利于患者术后的快速康复。
凌晨两点多,两台单肺移植手术相继完成。手术做完,外科医生的工作远没有结束。“外科医生的习惯是要看完所有的检查结果,心里才能真正踏实。”徐鑫说,考虑到第二天一大清早,还有四台肺移植将同时开启,几个人不约而同选择留在医院。
“当外科医生练就了倒头就睡的本领,因为太累了。”器官移植科病区主任彭桂林坦言,他们查看完患者的影像资料和验血结果等,索性就在值班房“挤”一晚,而这种场景对于器官移植团队来说并不罕见。

短暂休整后
四台肺移植同时开始
经过短暂休整之后,清晨不到七点钟,器官移植团队又开始了新一天的忙碌,供体小组成员分别前往佛山、梅州及广州的医院,三位因意外去世的患者,家人为他们做出器官捐献的决定,彰显人间大爱,这将为四位生命垂危的患者带来重生的希望。
在医院的手术室里,何建行教授根据手术安排,调配足够的人力,分为四个小组,几乎同时开始手术,在供体到达之前,他们需要完成前期各项准备工作,把已经没有功能的旧肺分离、切除,麻醉医生则需要时刻监测患者的各项指标,随时调整药物的剂量,确保患者术中安全。
73岁的老方(化名)患有间质肺多年,之前一直用药物规范治疗,能够维持在一个相对平稳的状况。然而,今年感染新冠病毒之后,他的病情出现进行性加重,每天需要靠吸氧维持呼吸,稍微活动一下就会感觉到气喘吁吁,步行最长的距离只能是从床边到厕所。
(患者术前影像检查资料)
在当地医院治疗两三个月没有好转,为寻求进一步治疗,他来到了广州医科大学附属第一医院,内科医生经过详细的评估之后,判断其已经具有肺移植指征。老方果断决定接受移植,他最大的愿望就是“手术之后,能继续唱歌跳舞”。

(器官移植团队在手术中)
为老方主刀的是何建行教授,作为器官移植方面的专家,他表示,患者的病情并不算是最糟糕的,不过由于患者年龄大、有基础病,所以要尽可能缩短手术时间,提高手术的安全性。
“患者心脏冠脉放置了支架,从血流动力学来讲会有一定的影响,我们在麻醉方面需要特别谨慎。”麻醉手术科主任蓝岚一直守在这里,盯着监测仪器,随时调整。不到三个小时,团队成功为老方完成了左肺移植手术。
就在老方的隔壁,是一位二次移植的患者,64岁的李叔(化名)多年前因终末期慢阻肺做了左肺移植,在何建行教授团队的精心治疗下,他术后很快恢复,生活质量大大提高,时常与老伴游山玩水。

(器官移植团队在手术中)
然而,由于新冠病毒感染,让他的右肺不堪重击,不得不又开始靠无创呼吸机度日,得知还有二次移植的机会,出于信任,他毅然决然选择回到这里,接受第二次命运的考验。这一次同样非常顺利,他千疮百孔的右肺得以换新。
在这四台肺移植手术中,36岁的小杨(化名)年纪轻轻,却已经被疾病折磨了十余年,可能与先天因素有关,让他二十多岁时就遭遇了难以根治的慢阻肺。在内科巨春蓉主任团队的系统治疗下,他的病情暂时得到控制。然而,去年底病情突然加重,出现呼吸衰竭,只能卧床依靠呼吸机,在家人的支持下,他依然决定要做双肺移植手术。

(器官移植团队在手术中)
尽管已经是终末期肺病,但在内科治疗维护下,他的身体基础还算合格,又在恰当的时候及时做出移植决定,经过术前评估,团队考虑具有术后手术室内拔管的基础,这对于双肺移植手术来讲,是一个不小的挑战。
同时接受双肺移植的另一位患者黎伯(化名)是呼吸内科的“老病号”,由于十几年的病程,已经将他的双肺摧残成马蜂窝状,大片空洞已经不可逆转,反复感染成为他的危险致命因素。

(患者术前影像检查资料)
今年初,不堪折磨的黎伯决定为自己搏一搏。但他的基础条件很差。内科团队巨春蓉说:“如果这个时候接受肺移植手术,风险很大”。于是,内科团队通过几个月的规范治疗,让他的身体终于“达标”,终于等到了移植手术的机会。

(器官移植团队在手术中)
这台手术却并不简单,支气管扩张患者在术中可能出血量比较大,两肺脓痰很多,需要一边手术一边配合吸痰,并且要小心不能污染到移植肺,医生在手术过程中也是煞费苦心。七个多小时过去,这台双肺移植手术顺利完成。

攀登新高度:
5例移植术后迅速改善肺功能
奔波、忙碌、紧张、喜悦交杂六场生命接力,承载着器官捐献者的大爱,在医护团队的默契配合下全部顺利完成,其中五例患者均实现术后迅速改善肺功能,目前,患者在ICU接受后续的密切监测和精心治疗,六人全部清醒。
肺移植是一个复杂的过程,术后带气管插管机械通气返回ICU是常规术后气道管理衔接步骤,在国际上绝大多数肺移植术后患者都需要戴着呼吸机进入病房,也就意味着手术后需要至少两天以上,肺功能才能恢复。但这样会存在长时间机械通气可能带来的气道损伤、继发感染等风险。
因而,能更早拔管,就意味着能更快离开ICU、返回普通病房,这是快速恢复的第一步。
何建行教授团队经过多年的临床经验积累,不断改进外科手术技术,并推动麻醉方式的变革,团队在完善的肺保护技术、全链条精细化管理、对供体和受体的精准判断、术后肺功能的准确评估等基础上,探索出肺移植术后在手术室内便可以拔除气管插管的创新之举,2018年成功完成国内首例。
随着技术的日臻成熟,大量的临床实践证明,我院器官移植团队已经充分把握肺移植术后手术室内快速拔管的技术要领,使快速康复能够在肺移植中得到精细化实施,术后移植肺可以迅速发挥功能,标志着整个肺保护技术、移植技术更上新台阶。
细微之处见功夫,毫厘之长定乾坤。作为国家肺移植医师培训基地、国家临床重点专科建设项目,广州医科大学附属第一医院器官移植科拥有丰富的临床经验和雄厚的技术实力,已经完成680多例肺移植手术,而在12小时内连续进行6台肺移植手术,4台同时开展充分体现了团队的“战斗力”。
“器官捐献来之不易,我们要把这份大爱延续下去,成熟的技术体系让我们有底气、有能力去挑战不可能。”
何建行教授表示,“器官移植的成功首先得益于伟大的爱心器官捐献,也得益于医院强大的综合实力,各学科无缝衔接,医护同心同力,不断攀登移植技术新高度,才能创造更多生命奇迹。”
来源:广州医科大学附属第一医院
责编:田栋梁
编辑:赵 静

